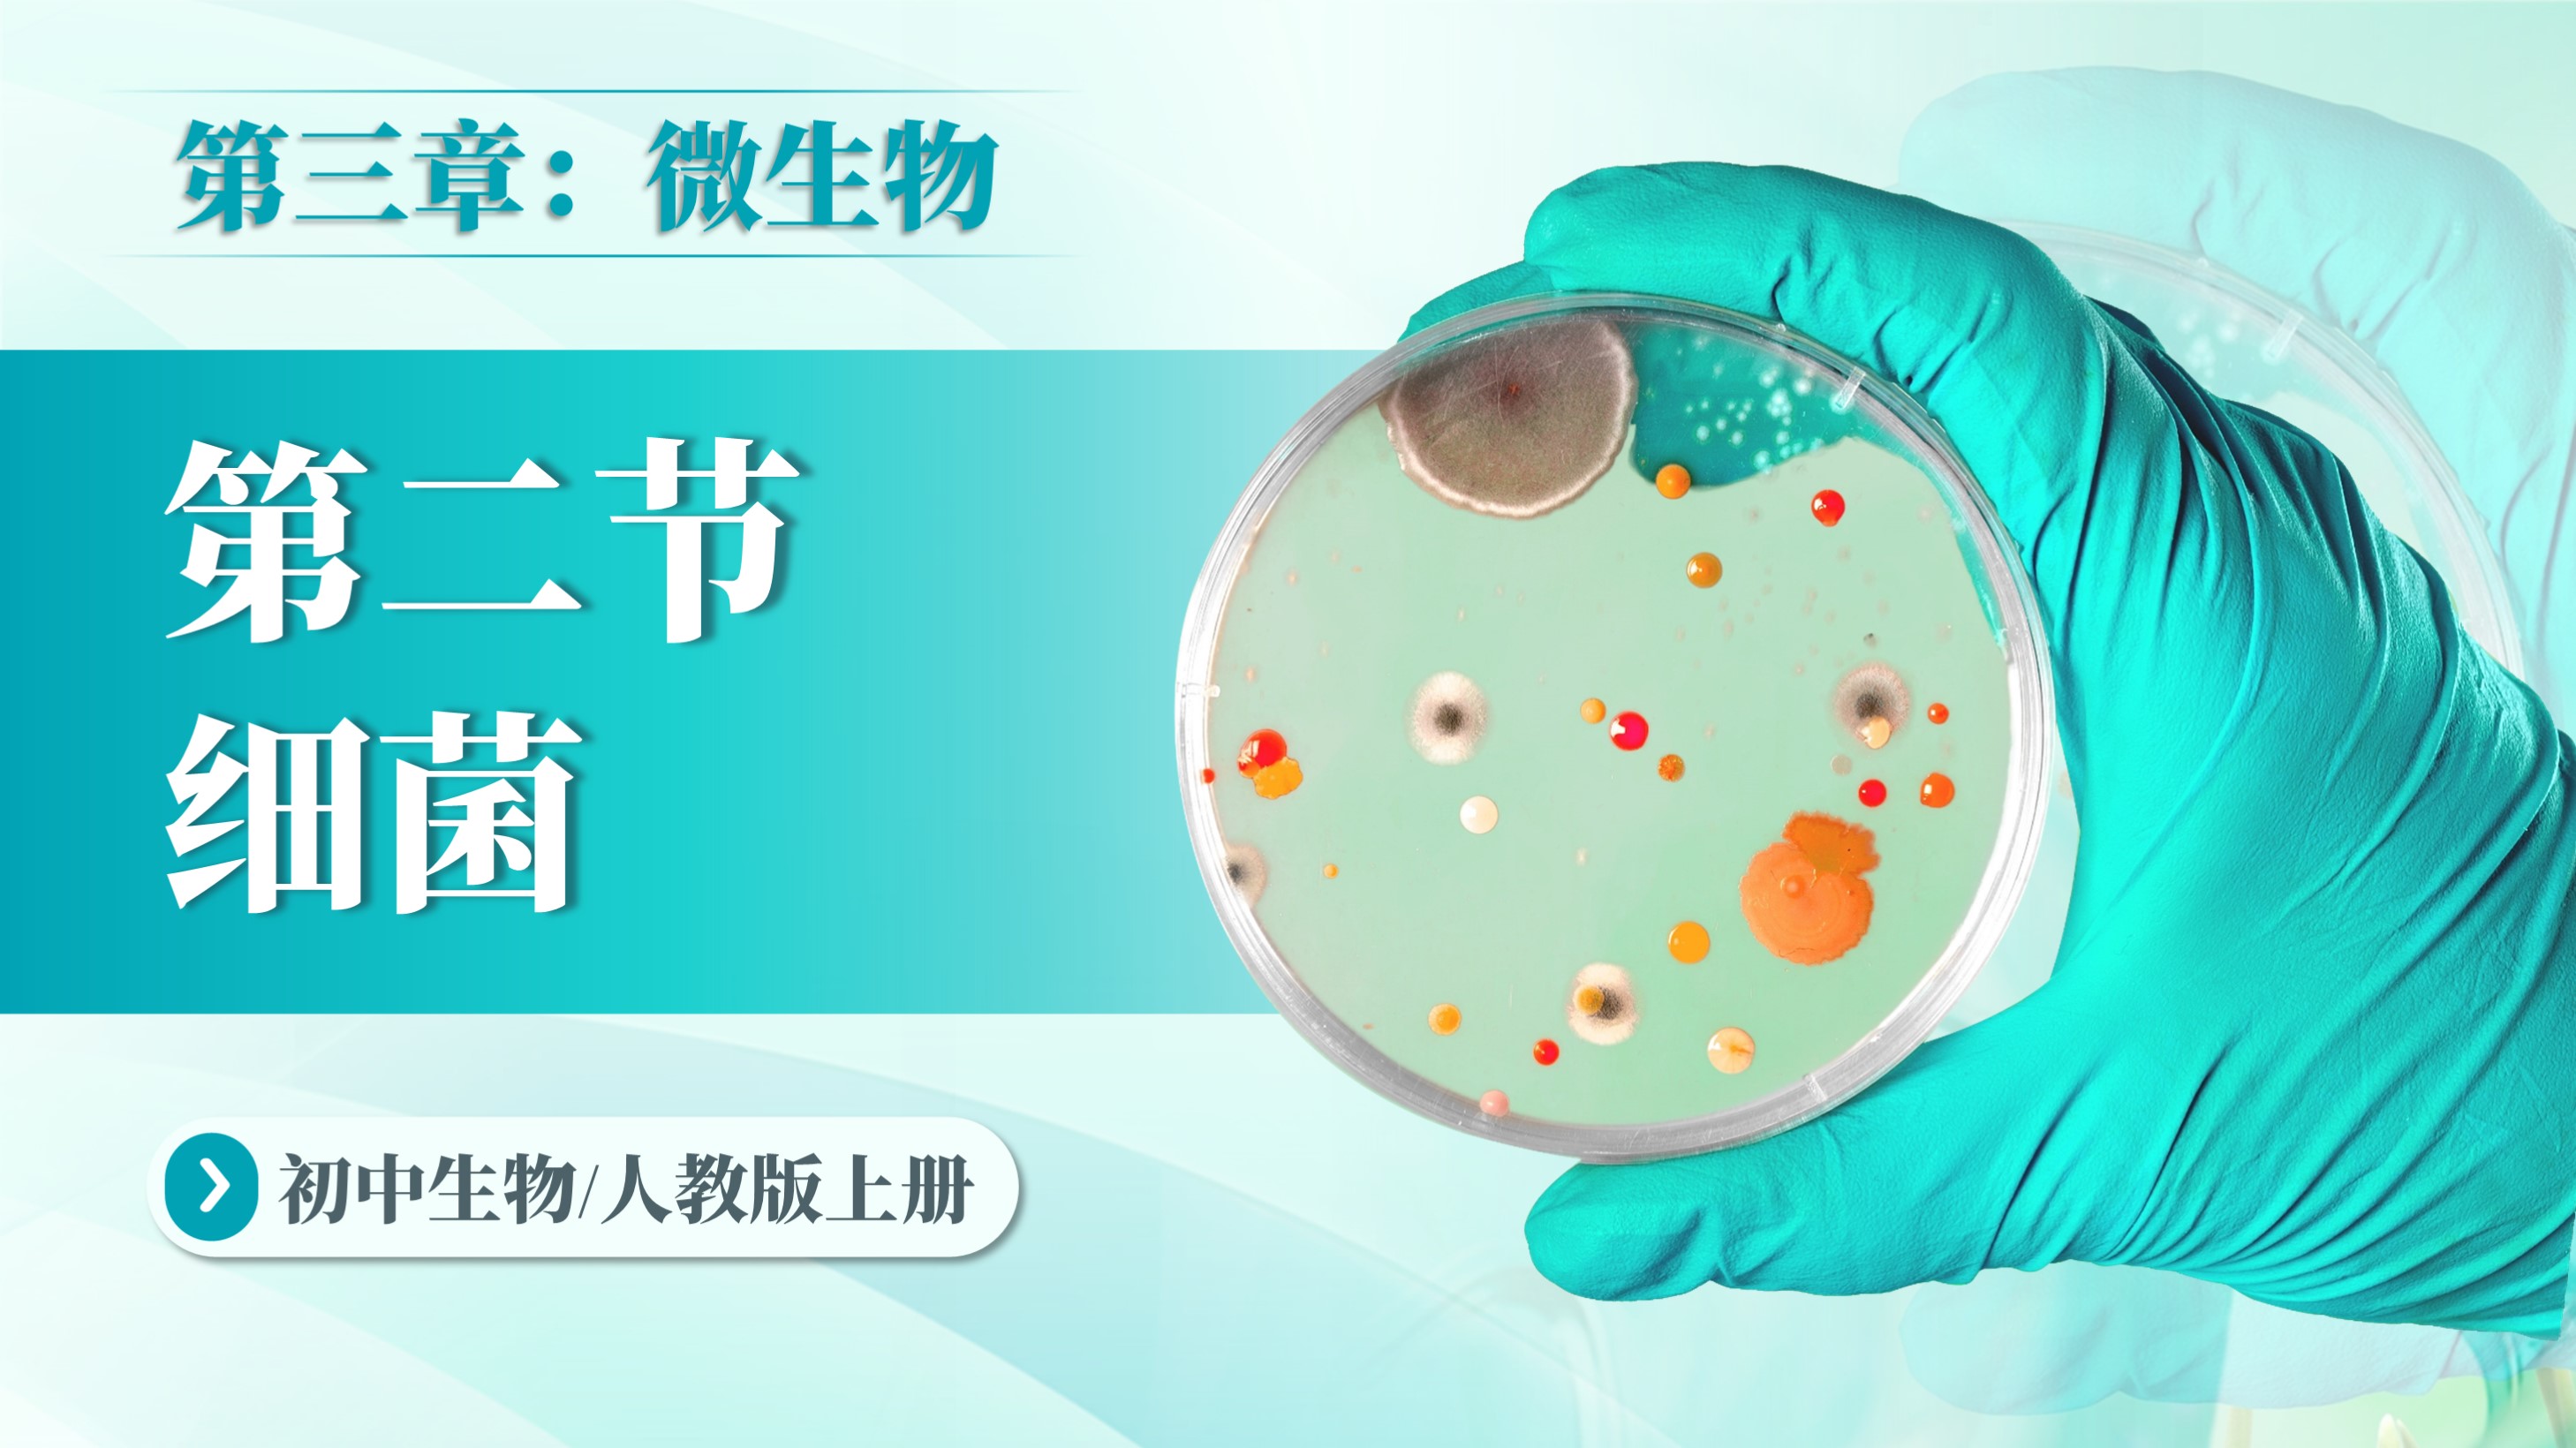
课件封面

My Account
Sign in now


联系客服

Flash Sale for Members
Add to computer desktop
Next time, you can quickly access 匠邦AI on the desktop


Add now
Scan the QR code on WeChat to experience it
Multi terminal data bidirectional synchronization

Download to Desktop
Activate Now
Membership not activated
0
Remaining gold coins
课件详情
返回
初中生物人教版七上第二单元第四章2.4《章节复习:生物分类的方法》
共1个附件 发布
浏览:197 下载:2

初中生物人教版七上第二单元第四章2.4《章节复习:生物分类的方法》
试看视频
常见问题
版本:

课本相关课件

【2025新】初中生物(人教版)《开学第一课》

初中生物人教版七上第一单元第一章第一节《调查周边环境中的生物》

初中生物人教版七上第一单元第一章第二节《生物的特征》

初中生物人教版七上第一单元第一章1.1《认识生物》章节复习

初中生物人教版七上第一单元第二章第一节《学习使用显微镜》

初中生物人教版七上第一单元第二章第二节《植物细胞》

初中生物人教版七上第一单元第二章第三节《动物细胞》

初中生物人教版七上第一单元第二章第四节《细胞的生活》

初中生物人教版七上第一单元第二章章节复习1.2《认识细胞》

初中生物人教版七上第一单元第三章第一节《细胞通过分裂产生新细胞》

初中生物人教版七上第一单元第三章第二节《动物体的结构层次》

初中生物人教版七上第一单元第三章第三节《植物体的结构层次》

初中生物人教版七上第一单元第三章章节复习1.3《从细胞到生物体》

初中生物人教版七上第二单元第一章第一节《藻类、苔藓和蕨类植物》

初中生物人教版七上第二单元第一章第二节《种子植物》

初中生物人教版七上第一单元第三章1.3.4《单细胞生物》

初中生物人教版七上第二单元第一章章节复习2.1-《藻类与植物类群》

初中生物人教版七上第二单元第二章第一节《无脊椎动物》

初中生物人教版七上第二单元第二章第二节《脊椎动物——鱼》

初中生物人教版七上第二单元第二章第二节《脊椎动物——两栖动物和爬行动物》

初中生物人教版七上第二单元第二章第二节《脊椎动物——鸟和哺乳动物》

初中生物人教版七上第二单元第二章章节复习2.2-《动物的类群》

初中生物人教版七上第二单元第三章第一节《微生物的分布》
初中生物人教版七上第二单元第三章第二节《细菌》

初中生物人教版七上第二单元第三章第三节《真菌》

初中生物人教版七上第二单元第三章第四节《病毒》

初中生物人教版七上第二单元第三章2.3《章节复习:微生物》

初中生物人教版七上第二单元第四章2.4.2《从种到界》

初中生物人教版七上第二单元第四章2.4.1《尝试对生物进行分类》

初中生物人教版七上第二单元第四章2.4《章节复习:生物分类的方法》